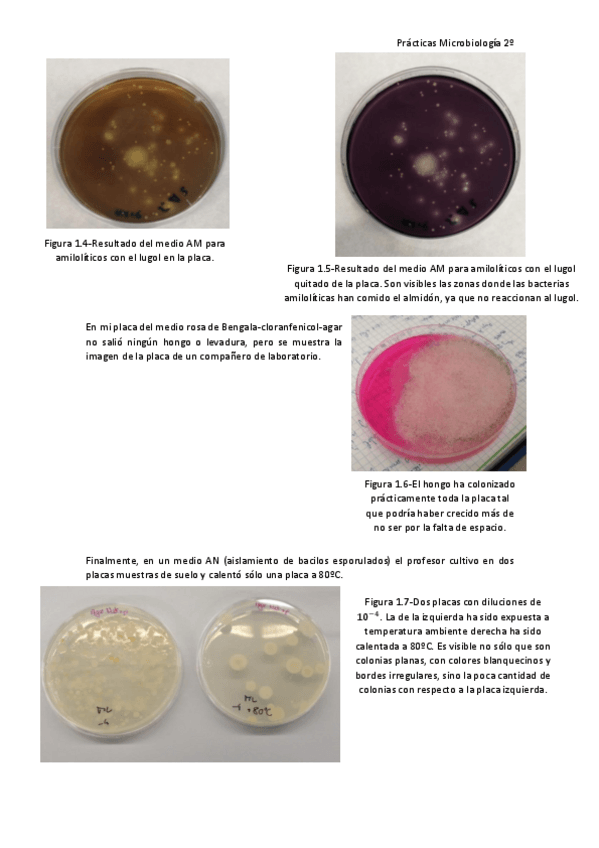

Microbiología General
trabajos
-
CUADERNO
He publicado nuevos trabajos de 2º Microbiología General: CUADERNO
He publicado nuevos apuntes de 2º Microbiología General: Microbiologia-TEMA-1.pdf
He publicado nuevos apuntes de 2º Microbiología General: Microbiologia-TEMA-1.docx
apuntes
-
Practicas
He publicado nuevos apuntes de 2º Microbiología General: Practicas
He publicado nuevos apuntes de 2º Microbiología General: Informe-de-practicas-microbiologia.pdf
He publicado nuevos examenes de 2º Microbiología General: PREGUNTAS-DE-TEORIA-ORDINARIA-2025.pdf
No es gran cosa pero te sirve mucho para aclarar las ideas sobre taxonomía, yo recomiendo hacerse este esquema.
apuntes
-
Microbiología General
He publicado nuevos apuntes de 2º Microbiología General: Microbiología General
He publicado nuevos apuntes de 2º Microbiología General: Microbiologia-completo.pdf
He publicado nuevos apuntes de 2º Microbiología General: Microbiologia-apuntes.pdf
He publicado nuevos test de 2º Microbiología General: Cuestionario-recopilacion.pdf
apuntes
-
Examen y apuntes micro 22-23
He publicado nuevos apuntes de 2º Microbiología General: Examen y apuntes micro 22-23
apuntes
-
Cuestinarios por temas Microbiología
He publicado nuevos apuntes de 2º Microbiología General: Cuestinarios por temas Microbiología
He publicado nuevos apuntes de 2º Microbiología General: Apuntes-micro-curso-2023-falta-tema-5.pdf
He publicado nuevos apuntes de 2º Microbiología General: WOLBACHIA-ELISA.pdf
He publicado nuevos apuntes de 2º Microbiología General: YERSINIA-ELISA.pdf
He publicado nuevos apuntes de 2º Microbiología General: VIBRIIONACEAE-ELISA.pdf
He publicado nuevos apuntes de 2º Microbiología General: Preguntas-Examen-Micro.pdf
He publicado nuevos apuntes de 2º Microbiología General: Apuntes-Micro-2-Cuatri.pdf
He publicado nuevos practicas de 2º Microbiología General: informe-de-practicas-microbiologia.pdf
He publicado nuevos examenes de 2º Microbiología General: Examen-micro.docx.pdf
He publicado nuevos practicas de 2º Microbiología General: Cuaderno-Micro-Practicas.pdf
He publicado nuevos practicas de 2º Microbiología General: Cuaderno-Practicas-Micro 22/23.pdf
He publicado nuevos practicas de 2º Microbiología General: Practicas-microbiologia.pdf
apuntes
-
Apuntes Microbiología
Apuntes en PDF completos hechos por el profesor Castro y enviados durante la cuarentena (Curso 2019/2020).
He publicado nuevos apuntes de 2º Microbiología General: Tipos-de-antimicrobianos-esquema.pdf
He publicado nuevos practicas de 2º Microbiología General: Practicas-Microbiologia.pdf